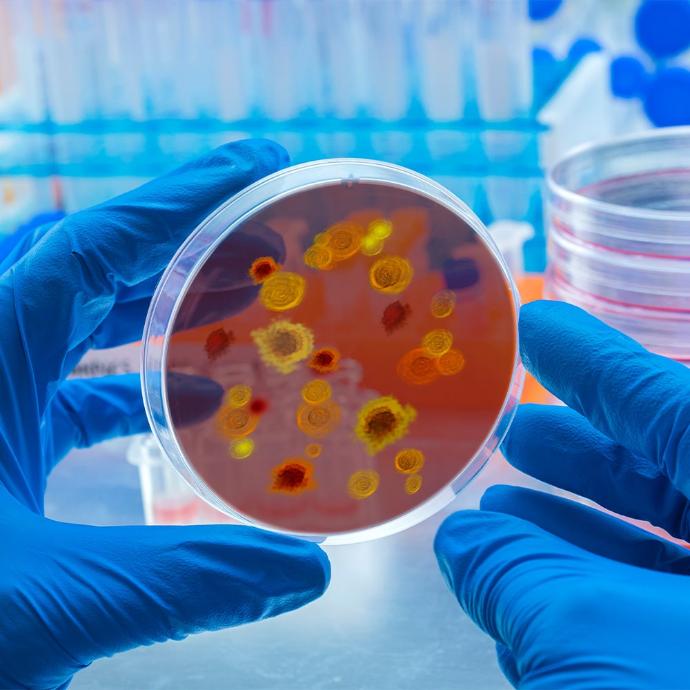
Biology and microbiology Biology and microbiology

For lab technicians: less stress, better focus
- Freedom from constant troubleshooting
With consistent temperature control and buttons that make sense, technicians can focus on meaningful tasks instead of wasting time troubleshooting a pointless frustration. - Fewer late nights and re-runs
Precise, dependable results mean no more wasted samples or extended hours repeating failed experiments. - Confidence in every result
Knowing your equipment works as expected reduces stress and helps you feel secure in your contributions.
For lab managers: peace of mind and less friction
- Stay on schedule, every time
Reliable water baths eliminate bottlenecks, keeping workflows on track and avoiding costly delays. - Happier, more productive teams
Technicians who aren’t battling failing equipment are more engaged and focused, reducing burnout and turnover. - Stretch your budget further
Durable, low-maintenance equipment means fewer repairs and replacements, giving you more room for other priorities. - Better lab performance
Consistent, high-quality results build your lab’s reputation and allow you to meet tight deadlines with less sweat.
For lab directors: trustworthy results and less risk
- A stronger lab reputation
Dependable equipment ensures your team delivers accurate, timely results, safeguarding your lab’s standing in the organization. - Smarter resource allocation
Investing in reliable water baths reduces hidden costs from repairs, lost samples, and inefficiencies, allowing you to direct funds where you prefer. - Regulatory peace of mind
With compliance-ready equipment, you’re less worried about audits. - Drive forward-thinking research
Reliable, high-performing equipment means your lab can tackle more ambitious projects for a greater impact.